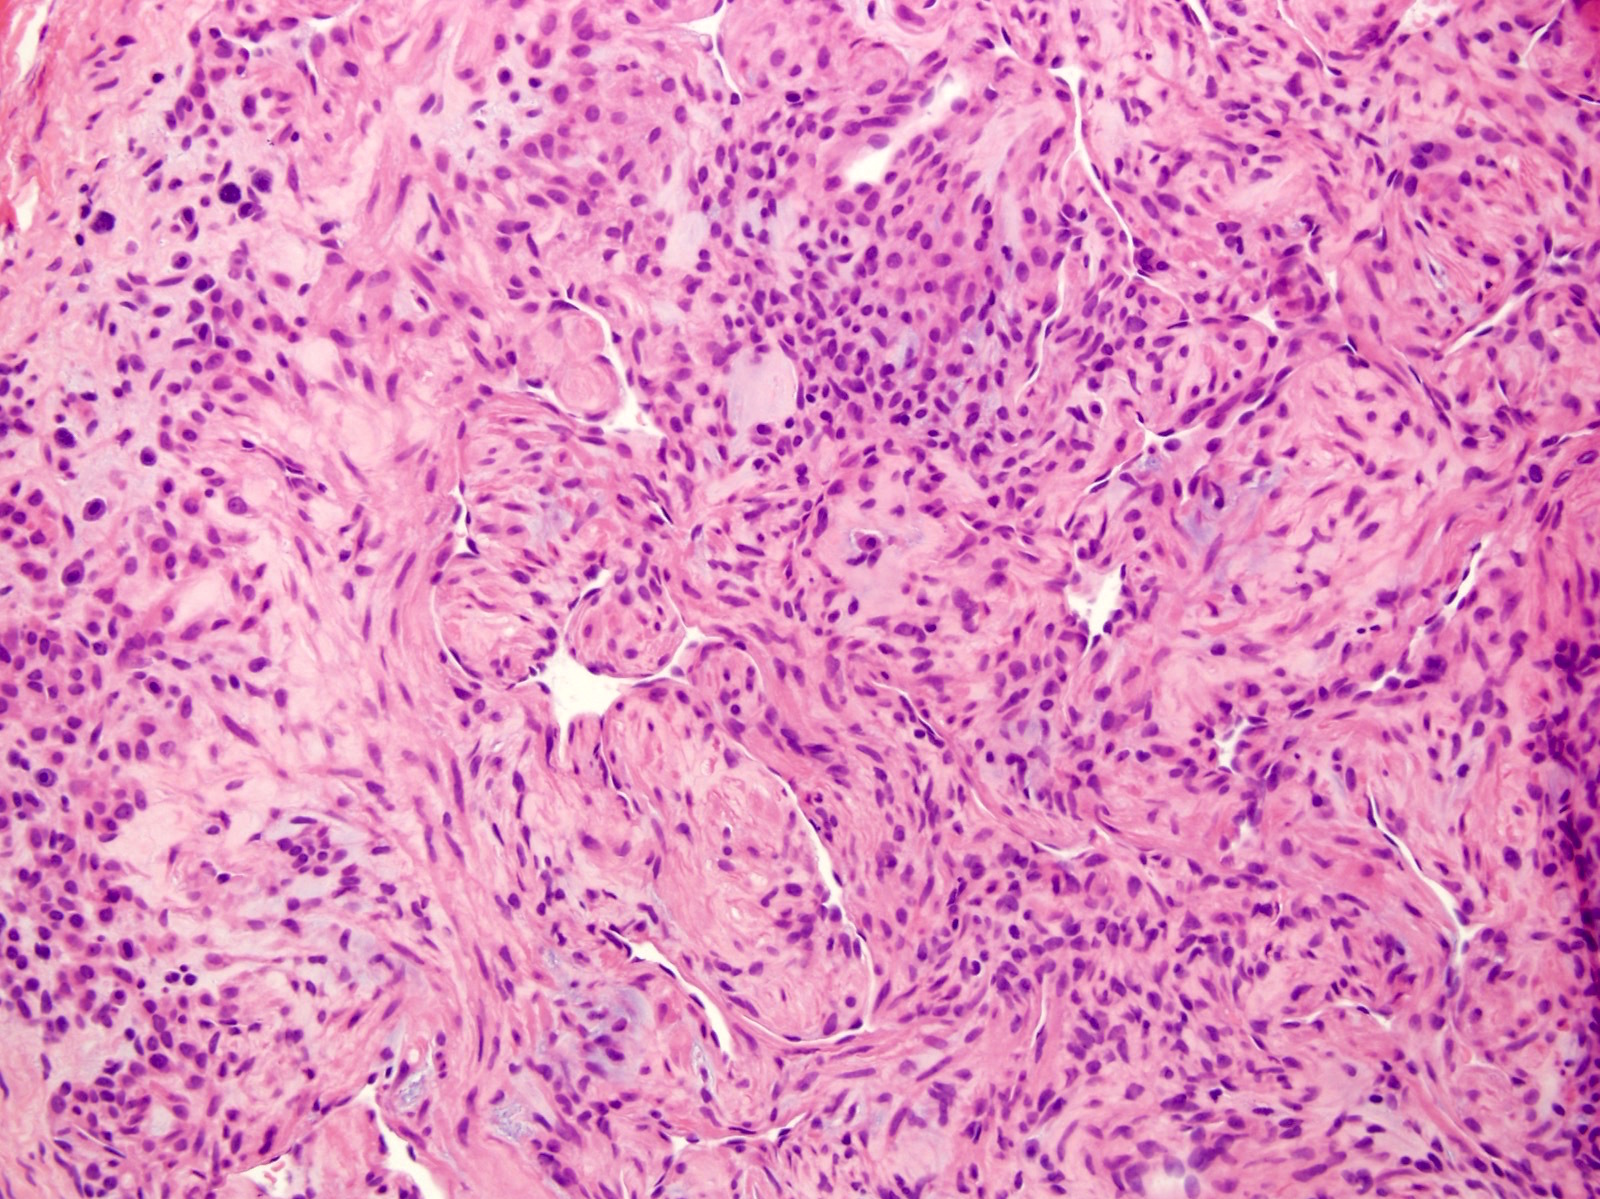

Table of Contents
Definition / general | Essential features | Terminology | ICD coding | Epidemiology | Sites | Pathophysiology | Etiology | Clinical features | Diagnosis | Radiology description | Radiology images | Prognostic factors | Case reports | Treatment | Clinical images | Gross description | Gross images | Microscopic (histologic) description | Microscopic (histologic) images | Cytology description | Cytology images | Positive stains | Negative stains | Electron microscopy description | Electron microscopy images | Molecular / cytogenetics description | Molecular / cytogenetics images | Sample pathology report | Differential diagnosis | Practice question #1 | Practice answer #1 | Practice question #2 | Practice answer #2Cite this page: Obeidin F, Alexiev BA. Glomus tumor. PathologyOutlines.com website. https://www.pathologyoutlines.com/topic/softtissueglomus.html. Accessed September 30th, 2025.
Definition / general
- Mesenchymal tumor composed of modified smooth muscle cells that arise from the glomus body
Essential features
- Predominantly cutaneous; most common in subungual region of the finger but may occur anywhere
- Usually benign with very rare malignant variants
- Combination of glomus cells, smooth muscle cells and vasculature
- Round, punched out nuclei with amphophilic to eosinophilic stroma surrounding branching, capillary sized vessels
- Positive for SMA, MSA, calponin, h-caldesmon, collagen type IV; negative for cytokeratin and S100
Terminology
- Name differs based on morphology: glomus tumor, glomangioma, glomangiomyoma and glomangiomatosis
- Malignant glomus tumors are also called glomangiosarcoma
- Note: certain site specific misnomers like glomus faciale, glomus jugulare, glomus tympanicum, glomus vagale, etc. are actually paragangliomas (N Engl J Med 2002;347:854)
- Glomangiopericytoma may be used for glomus tumors with prominent hemangiopericytic vasculature; however, these tumors are different from the pericytic site specific sinonasal glomangiopericytoma
ICD coding
- ICD-10: D21.10 - other benign neoplasms of connective and other soft tissue
Epidemiology
- Estimated incidence of 1.6% of soft tissue tumors (Surg Gynecol Obstet 1963;117:334)
- Most occur in adults aged 20 - 40
- Equally common in both genders; subungual lesions have a female predominance of 3:1 (Cancer 1982;50:1601)
Sites
- Described throughout the body; most common is upper extremity (62%), particularly the fingers (27%)
- Subungual region is the most common location on the finger
- Other sites:
- Trunk wall (11%)
- Internal (11%)
- Lower extremity (9%)
- Head and neck (7%)
- Atypical and malignant glomus tumors are more commonly deep seated than benign tumors (Am J Surg Pathol 2001;25:1)
Pathophysiology
- NF1 associated tumors arise from biallelic inactivation of NF1 (Cancer Res 2009;69:7393)
- Loss of neurofibromin in glomus cells leads to activation of the RAS-MAPK pathway
- Familial glomus tumors (glomuvenous malformations) are caused by inactivating mutations in the glomulin gene expressed in vascular smooth muscle cells (Am J Hum Genet 2013;92:188)
- Some cases show novel translocation resulting in oncogenic activation of NOTCH driven by translocation with the MIR143 promoter (Genes Chromosomes Cancer 2013;52:1075)
Etiology
- Arises from the Sucquet-Hoyer canal of the glomus body, a specialized arteriovenous anastomosis that regulates heat in the skin and is surrounded by layers of epithelioid, SMA+ glomus cells
- Cold temperature causes relaxation of the glomus cells to open the anastomosis and divert blood away from the capillary network to conserve body heat (J Med Genet 2010;47:525)
Clinical features
- Symptoms:
- Paroxysms of pain radiating away from the lesion, often out of proportion to the size of the neoplasm
- Pain can be elicited by changes in temperature or tactile stimulation
- Can be accompanied by hypesthesia, muscle atrophy or osteoporosis
- Some glomus tumors of the fingers and toes are associated with NF1 (J Med Genet 2010;47:525)
Diagnosis
- Clinical and location may be highly suggestive
- Definitive diagnosis requires histologic assessment of the tumor by biopsy or excision
Radiology description
- MRI: well defined mass, dark on T1 and bright, contrast enhancing on T2 or T1 post gadolinium fat saturation images
- MR angiography: strong enhancement in the arterial phase and tumor blush, which increases in size in the delayed phase
- Ultrasound: solid, hypoechoic mass with possible associated erosion of the underlying bone (Radiographics 2010;30:1621)
- Radiography: may show thinning of the cortical bone in subungual tumors (AJR Am J Roentgenol 2004;182:263)
Radiology images
Prognostic factors
- Benign tumors have a small chance for recurrence if incompletely excised
- Atypical features found to correlate with adverse outcome; can be called glomus tumor of uncertain malignant potential:
- Deep location, size > 2 cm and the presence of atypical mitotic figures
- Malignant glomus tumors are characterized by (1) marked nuclear atypia and any level of mitotic activity or (2) atypical mitotic figures and metastasize in up to 40% of cases (Am J Surg Pathol 2001;25:1)
Case reports
- 24 year old woman with a gastric mass (Niger J Surg 2020;26:162)
- 28 year old man with an index finger mass (Autops Case Rep 2020;10:e2020184)
- 30 year old woman with an ulnar digital nerve mass (Plast Reconstr Surg Glob Open 2019;7:e2053)
- 36 year old woman with unilateral hearing loss and a middle ear mass (World J Otorhinolaryngol Head Neck Surg 2019;5:175)
- 56 year old man with left thigh pain and a palpable subcutaneous mass (Int J Surg Case Rep 2020;75:352)
- 65 year old man with a 0.7 cm dermal buttock mass (Dermatol Pract Concept 2019;9:318)
Treatment
- Benign tumors cured by complete surgical excision; recurrence rate of 10% likely due to incomplete resection (Arch Pathol Lab Med 2008;132:1448)
- Direct transungual excision is the standard but can cause nail deformity; lateral subperiosteal approach reduces risk of nail deformity but may slightly raise risk of recurrence (Plast Reconstr Surg 2004;114:1486)
- No clinical trial data is available for treatment of malignant glomus tumors but doxorubicin and olaratumab have been approved for recurrent / metastatic disease
- No prospective data exists yet for Notch inhibition or immune checkpoint inhibitors
Clinical images
Gross description
- Bulging mass with an irregular, nodular hemorrhagic cut surface
- Superficial lesions typically < 1.0 cm
Gross images
Microscopic (histologic) description
- Well circumscribed mass composed of 3 components: glomus cells, vasculature and smooth muscle cells
- Solid glomus tumor (75% of cases): predominantly glomus cells, poor vasculature and rare smooth muscle cells
- Glomangioma (20% of cases): tumors with prominent vascular component
- Glomangiomyoma (5% of cases): tumors with prominent vascular and smooth muscle components
- Rare variants have microscopically infiltrative and diffuse growth and are known as glomangiomatosis
- Benign glomus tumors (Arch Pathol Lab Med 2008;132:1448):
- Branching capillary sized vessels lined by endothelial cells surrounded by collars of uniform glomus cells forming nests, sheets and trabeculae in a hyalinized or myxoid stroma
- Glomus cell has a round shape with indistinct borders with a rounded, sharply punched out nucleus in an amphophilic to eosinophilic cytoplasm
- Chromatin is homogenous and bland with inconspicuous nucleoli
- Very rare mitoses
- Symplastic glomus tumor:
- Marked nuclear atypia with no mitotic activity or other atypical features
- Does not affect prognosis
- Malignant glomus tumor (Am J Surg Pathol 2001;25:1):
- Diagnosis should be reserved for tumors showing (1) marked nuclear atypia and any level of mitotic activity or (2) atypical mitotic figures
- May be spindled and resemble leiomyosarcoma / fibrosarcoma or may consist of sheets of malignant appearing round cells
- Benign glomus tumor component can often be found at the periphery and help with diagnosis
- Glomus tumor of uncertain malignant potential:
- Tumors that do not fulfill criteria for malignancy but have at least 1 atypical feature other than nuclear pleomorphism
- Atypical features include deep location, size ≥ 2 cm and mitotic activity > 5 mitoses/50 high powered fields
- Oncocytic features have been described (Histopathology 1987;11:523)
Microscopic (histologic) images
Contributed by Farres Obeidin, M.D.
Case #289
Case #238
Cytology description
- Cohesive clusters of uniform round cells with scanty cytoplasm
- Background of scattered amorphous magenta colored material, blood and occasional inflammatory cells (J Cytol 2010;27:104)
Cytology images
Positive stains
- Vimentin (100%), smooth muscle actin (99%), muscle specific actin (95%), calponin (80%), CD34 (32 - 53%; typically focal) (Int J Surg Pathol 2015;23:181)
- Collagen type IV, laminin (91%; pericellular), h-caldesmon (87%) (Am J Surg Pathol 2002;26:301)
Negative stains
Electron microscopy description
- Thick basal lamina surrounds individual glomus cells except at cellular junctions
- Pinocytic vesicles and myofibrils with dense bodies in the cytoplasm (Cancer 1969;23:1176)
Molecular / cytogenetics description
- MIR143-NOTCH gene fusions in more than half of benign and malignant glomus tumors; can be evaluated by FISH (Genes Chromosomes Cancer 2013;52:1075)
Sample pathology report
- Thumb, mass, excision:
- Glomus tumor, excised (see comment)
- Comment: Histologic sections demonstrate a dermal, solid and syncytial proliferation of round cells with punched out nuclei surrounding scattered blood vessels with perivascular hyalinization. No mitotic activity, necrosis or nuclear atypia is noted. SMA and desmin IHC are positive and keratins are negative, supporting the diagnosis.
Differential diagnosis
- Myopericytoma and other pericytic tumors:
- Derived from perivascular cells and may lie on a spectrum with glomus tumors
- Can have histologic and immunohistochemical overlap in areas with more prominent spindled differentiation
- Benign adnexal tumors, like nodular hidradenoma / eccrine spiradenoma:
- Paraganglioma:
- Prominent Zellballen growth pattern, positivity for synaptophysin and chromogranin and S100 positive sustentacular cells
- Neuroendocrine tumor:
- Salt and pepper chromatin, negative for SMA and positive for keratin, synaptophysin and chromogranin
- Dermal nevus:
- Nests of melanocytes, with or without pigmentation, lacking association with blood vessels
- S100 positive, melanocytic markers positive, SMA negative, h-caldesmon negative
- Angioleiomyoma:
- Bundles of smooth muscle cells that lack a prominent round cell component
- Desmin typically positive
Practice question #1
Practice answer #1
A. Complete surgical excision is curative. This is a glomangioma, a variant of glomus tumor. It is a benign tumor and if completely excised, surgical excision is essentially curative. The most common location is in the subungual region of the finger. Though it may show focal positivity for CD34, the staining for CD31 and ERG will be negative as the tumor cells are not vascular in origin.
Comment Here
Reference: Glomus tumor
Comment Here
Reference: Glomus tumor
Practice question #2
- Which of the following molecular aberrations can be seen in glomus tumors?
- ETV6-NTRK3
- EWSR1-FLI1
- MIR143-NOTCH1
- SS18-SSX2
Practice answer #2
C. MIR143-NOTCH1. Over 50% of glomus tumors harbor gene fusions of MIR143 with either NOTCH1 or NOTCH2.
Comment Here
Reference: Glomus tumor
Comment Here
Reference: Glomus tumor